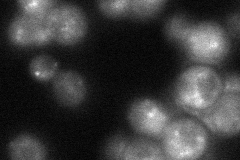
YJL154C

View description
Endosomal subunit of membrane-associated retromer complex required for retrograde transport; receptor that recognizes retrieval signals on cargo proteins, forms subcomplex with Vps26p and Vps29p that selects cargo proteins for retrieval
Localization:
Intensity:
Fold change:
Significance:
-
C’ GFP library in SD

punctate:vacuole membrane47.08 -
N' NOP1pr-GFP in SD

cytosol,punctate67.6792 -
N' TEF2pr-mCherry in SD

punctate,nuclear periphery19.5854 -
N' NATIVEpr-GFP in SD
punctate44.2297 -
N' TEF2pr-VC and Cyto-VN in SD

cytosol27.2498 -
C’ GFP library in SD+DTT

punctate.vacuole membrane52.431.11No -
C’ GFP library in SD+H2O2

punctate.vacuole membrane47.211No -
C’ GFP library in Starvation Media

punctate,vacuole membrane56.731.2No -
C’ GFP library on the background of Pup2-DaMP

punctate:vacuole membrane -
C’ GFP library on the background of CCT mutant

punctate:vacuole membrane50.33571.06911No
